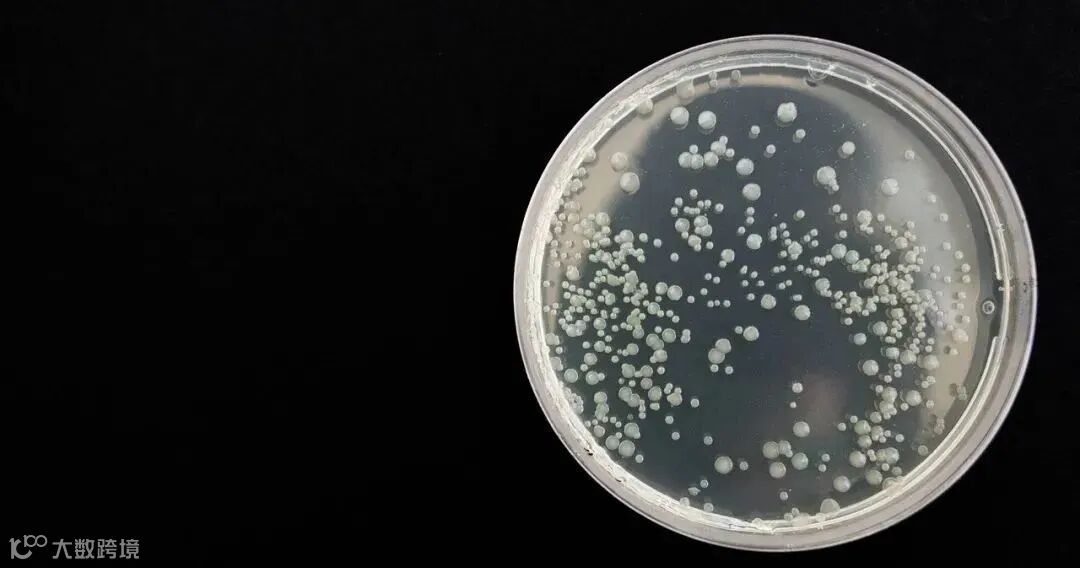

本文根据《中国合成生物学2035发展战略》一书改写而成
文章回顾了合成生物学的发展历程并探讨其学科内涵;多方位反映合成生物学的发展现状及其促进“会聚”研究的科学意义与提升人类“能力”的战略价值;深入分析该新兴学科自 21世纪初创立到今天逐步厘清的关键科学问题、技术瓶颈及社会核心需求,探讨了未来突破与拓展的重点发展方向;为进一步强化合成生物技术战略科技工程力量,推动我国合成生物学高质量发展,合成生物学及“会聚”研究的生态建设,以及高效率服务科技与社会发展,提供政策建议的参考。

赵国屏 中国科学院院士
文章将陆续就合成生物学的发展现状、合成生物学未来发展的重点技术、合成生物学未来的应用领域等章节重要分享。
合成生物学的发展现状
合成生物学所具有的革命式、颠覆式创新潜力,已经成为世界各国必争的科技战略高地,正在引发新一轮科技与产业国际竞争。
美国、英国、澳大利亚、欧盟等国家和地区不断更新和发布相关的研究和技术路线图,加大经费投入并持续支持新的研究项目,建立合成生物学/工程生物学研究中心和平台设施等。在巨大的研发及产业转化努力背景下,合成生物学的应用迅速向材料、能源等社会经济重要领域和医药、农业、食品等人民健康相关领域拓展,正在形成一个新兴的“产业方向”,甚至有可能形成新兴的“投资生态圈”。
合成生物学2021年全年总共完成近180亿美元的融资,几乎相当于2009—2020年所有融资额的总和。而随着新冠疫情的全球大流行,合成生物学在医疗健康领域、食品营养领域的应用也更加受资本青睐。
在我国,中央政府部门和科技界高度重视合成生物学的研究。“十二五”期间,国家重点基础研究发展计划(973计划)、国家高技术研究发展计划(863计划)战略布局了合成生物学的系统发展,并于2018年启动首个国家重点研发计划“合成生物学”重点专项。
经过多年发展,我国在合成生物学领域的科学研究、平台设施建设、国际交流合作等方面都取得了长足进步,不仅出现了“创造”世界首例单条染色体真核细胞、二氧化碳到淀粉的从头合成等重大科技进展和突破,2020年以来我国的合成生物学初创公司更是迅速发展,投融资高度活跃。
在取得显著成绩的同时,应该看到,我国在合成生物学领域的底层创新、成果转化和科研生态等方面与国际领先水平还存在差距,尤其是核心基础理论的突破和关键工程技术的创新有待提高,资源平台和工具的研发及共享有待加强,促进“会聚”和“转化”的激励及评价等政策有待建立和完善。
合成生物学未来发展的重点技术
为充分把握合成生物学领域的国际发展态势和国家战略需求,需进一步明晰我国合成生物学领域的发展思路、发展目标、优先发展领域及重要的研究方向。
合成生物学的核心科学问题,一方面是解答生命体系结构相变加功能涌现的原理,另一方面是基于上述原理解决生命系统的理性设计与构建的瓶颈问题。合成生物学的定量研究方法包括基于“定量表征+数理建模”的白箱模型与基于“自动化+人工智能”的黑箱模型。定量合成生物学有望推动基础生命科学与合成生物学的双重变革。
合成生物学的重点技术主题包括基因编辑、合成与组装,设计技术,细胞工程,合成生物学先进分析技术,以及合成生物数据库、大数据智能分析与自动化实验五个方向。
(1)
基因编辑、合成与组装
基因组编辑技术是合成生物学的一项核心使能技术。CRISPR基因组编辑技术在生命科学领域掀起了一场全新的技术革命,但目前CRISPR基因组编辑技术的性能尚有欠缺,智能设计、表达和递送系统等技术还不能满足医疗等应用需求。未来基因组编辑技术的发展,一方面亟待开发更精准、高效、全面和智能的CRISPR基因组编辑技术;另一方面需利用大数据分析和人工智能技术,不断开发全新的颠覆性基因组编辑技术。

DNA组装技术是合成生物学的重要基础。随着对 DNA序列长度需求的增加,对DNA组装技术也提出更高要求,尤其是快速发展的基因组设计合成领域,需要超大DNA片段的组装技术的支撑。体外拼装的片段大小虽然已可达几百kb(kb为DNA的一个常用单位,指某段DNA分子中含有1 000个碱基对),但所得的量依然不足以进行后续实验,在未来的研究过程中,需要开发更加高效的组装方法。大尺度DNA分子组装未来需要不断提高组装效率,降低其组装成本并且拓展其组装能力,开发新的分子生物学工具,突破长度更大、复杂程度更高的大DNA组装技术等。
DNA信息存储提供了一种新的存储模式,但其在应用方面仍面临很多挑战。未来发展需要从高效率高质量直接“编”码、低成本高通量信息“写”入、稳定高兼容性分子信息“存”储、实时永久性信息稳定“读”取等方向实现突破。随着DNA信息存储各个问题的逐步解决,或将打开全球海量数据存储的新纪元。
(2)
设计技术
蛋白质结构预测和功能设计致力于解决根据结构设计序列以及根据功能设计结构两个重大问题,其终极目标是利用计算机算法,设计具有所需功能且能够折叠成特定结构的蛋白质。未来一段时间,需要着重发展恰当描述主链运动和更加精确描述侧链构象的表示方法,提高能量函数的准确性和通用性,构建高质量蛋白质标注数据集,推进蛋白质计算设计软件的国产化,摆脱长期以来对国外软件的依赖,构建自主可控的蛋白质计算设计平台。
人工基因回路设计与构建促进了人们对生命调控基本规律的认识,丰富了对天然生物系统改造、从头设计的手段。然而,人工基因回路与底盘细胞的各种相互作用,却阻碍了人工设计生命系统复杂度的进一步提升。未来研究应重点关注:拓展更加多样的调控元件,开发基于转录组、蛋白质组等多层次的高通量技术,开发新型的全细胞模型,研发元件-宿主隔离技术和策略,开发植物和哺乳细胞等高等生物的基因线路移植和定量表征技术等。
生物合成途径设计的发展,极大提升了生物合成途径的挖掘效率以及微生物细胞工厂的优化效率。随着人工智能与机器学习等技术的进步,未来的生物合成途径设计中需要构建智能化信息更新、可共享的细胞代谢和酶催化数据资源库,研究适用于生物逆合成预测的化合物结构数字化描述方法,解析微生物细胞工厂在不同发酵环境下的组学规律,挖掘并整理与细胞相关的化合物毒性和转运数据库,优化完善细胞模型和代谢数据库,开发高版本数字细胞模型与生物逆合成途径算法等。
(3)
细胞工程
无细胞系统未来发展中,需进一步优化以提高效率、降低成本,同时提高生物大分子合成的个性化、多样化、普适性和稳定性;使用寿命需进一步延长,朝着能够实现自我复制的无细胞合成系统迈进。
单细胞工厂未来需要开发通用性底盘细胞,以及高通量、自动化实验技术,实现对细胞工厂的理性设计。微生物组工程应重点发展微生物群落的原位编辑工具,开发微生物群落的精准调控方法,理解合成微生物群落的设计原则,指导构建可控、稳定的微生物互作网络,探索复杂微生物群落的基本科学规律,同时致力于解决人类健康、农业生产等领域的重要问题。
非天然系统目前普遍存在翻译效率低、正交性和兼容性差等核心瓶颈。未来研究的重点和难点应针对翻译系统中多种翻译元件的系统性优化改造乃至从头设计,构建具有多个空白密码子的底盘细胞;针对翻译工具和底盘细胞的相互适配原则的探索与优化改造,以及结合这些研究内容实现多种非天然氨基酸在基因组上同时编码。
(4)
合成生物学先进分析技术
多组学技术中,蛋白质组学的发展将主要围绕蛋白质解析技术、新型蛋白质修饰解析技术、定量蛋白质组鉴定分析、超高分辨率解析技术等展开;代谢组学优先发展的方向包括创新发展分析方法、拓展代谢研究的空间维度、建立代谢计算平台等。
单细胞技术作为一种细胞功能测试的新手段,需要重点拓展单细胞代谢表型组的应用,开发“靶标分子特异性”与“全景式表型测量”兼顾的单细胞光谱成像,实现单细胞“成像-分选-测序-培养-大数据”全流程的标准化、装备化与智能化。
传感技术则需开发代谢物荧光传感普适性技术、多参数单细胞代谢传感技术、生物正交细胞代谢光遗传学控制技术,以及全光型大规模多参数单细胞代谢表型分析技术。
活体成像技术未来发展主要包括打破超分辨率成像的时空分辨率极限、实现多模态全景超分辨率成像、发展高通量超分辨率成像、攻关成像核心材料器件、深化深度学习显微成像以及设计更好的新型成像探针。
类器官芯片技术需构建典型的类器官芯片系统,促进与多组学技术的深度融合,未来实现“类人”的生命模拟系统构建,以及针对个体化的疾病风险预测、药物药效评价、毒理评估和预后分析。
(5)
合成生物数据库、大数据智能分析
与自动化实验
现有的合成生物数据库/知识图谱分散、内容完整度差、缺乏统一标准,如何构建标准化合成生物数据库,构建全面、准确的合成生物知识图谱,是亟待解决的关键技术问题。
未来,在合成生物数据库和知识图谱方面,需要建立适应大数据时代的新技术和资源体系,建设面向合成生物研究的数据仓库、数据库和知识图谱等,用于合成生物大数据的标准化存储、共享和挖掘分析等;在数据智能分析方面,需要深度集成传统生物信息技术与新型人工智能方法,实现数据驱动的“设计-构建-测试-学习”智能闭环,在系统建模、异构数据集成、智能设计与功能预测等方面实现关键技术突破。
文章来源:《中国合成生物学2035发展战略》
往期推荐









